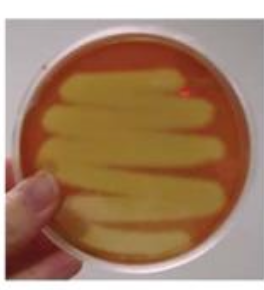
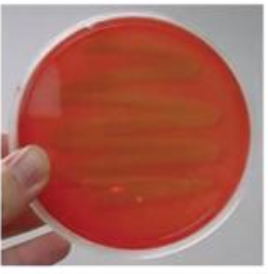
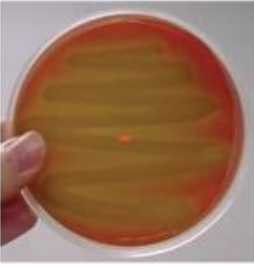

¿Cuál es la clasificación de los estreptococos?
Alfa, beta, gamma –> hemolisis
El metabolismo de los estreptococos es:
Anaerobia facultativa
Los estreptococos estas dispuestos en:
Diplococos y cadenas largas
Son: Gramm ____ , catalasa _____ .
Gramm positivas, catalasa negativa.
En esta destrucción completa de los heritrocitos se llama:
Beta hemolisis
En esta destrucción nula de los heritrocitos se llama:
Gamma hemolisis
Aqui observamos una actividad incompleta de:
Alfa hemolisis
El Streptococcus pyogenes pertenece a:
Estreptococo tipo A
El Streptococcus agalactiae pertenece a:
Estreptococo tipo B
¿Qué es la hemolisis?
Los glóbulos rojos son destruidos de manera prematura o en grandes cantidades por la presencia de una bacteria.
Clasificación por optoquina
Sensible: _____
Resistente: ____
1.- S.pneumoniae
2.- S. viridans
Clasificación por bacitracina
Sensible: _____
Resistente: _____
1.- S. pyogenes
2.- S. agalactiae
¿Donde encontramos la proteína M del S. pyogenes?
1.- En las fimbrias que permite la adhesión
2.- ayuda a evitar la fagocitosis
3.- proyectada al exterior de la bacteria y anclada a la pared de la bacteria.
¿Qué son las invasinas?
Facilitan la entrada de las bacterias a las células del cuerpo humano, superando las barreras físicas del organismo y facilitando la colonización de tejidos
¿Qué proceso pueden utilizar las invasinas para facilitar la colonización de bacterias?
Procesos de endocitosis
A qué grupo pertenece el S. pyogenes?
GAS hemolítico del grupo A.
El S. pyogenes produce cadenas:
Cortas
¿Cuál es su antígeno en la pared celular?
Antígeno A (N-acetilglucosamina/ramnosa)
¿Que causan las Cepas encapsuladas del S. pyogenes?
Causan infecciones sistémicas graves
Se le llama bacteria come carne porque…
Produce varias exotoxinas y tienes muchas enzimas invasoras (invasinas)
El S. pyogenes Posee Capsula de:
Ácido hialurónico = manera de esconderse.
¿Qué hace la peptidasa C5a?
Evita quimotaxis de fagocitos
¿Qué son las toxinas Spe?
1.- Toxinas pirógenas estreptocócicas …
2.- son superantígenos de la misma familia que las toxinas estafilocócicas.
¿Qué es un super-antígeno?
1.- Antígeno que provoca una activación excesiva e inespecífica del sistema inmunológico, especialmente de los linfocitos T,
2.- causando una liberación masiva de citocinas (proteínas que regulan la respuesta inmune),
3.- resulta en una tormenta de citocinas y graves consecuencias para el organismo





